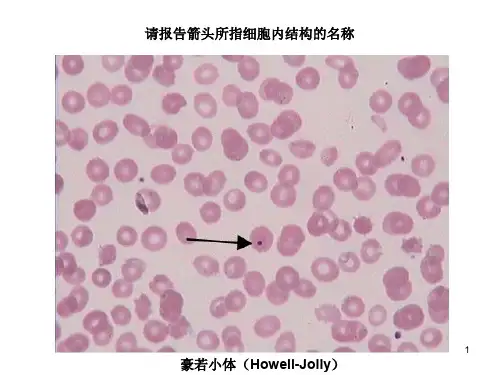

❖ 绘制各种不同类型的血细胞,并说明它们 的主要作用;
❖ 任选20个红细胞,测量其直径,并计算 出平均值。
精选课件
25
感谢亲观看此幻灯片,此课件部分内容来源于网络, 如有侵权请及时联系我们删除,谢谢配合!
2.将镜台测微尺盖片面朝上放在载物台上,用低倍镜 观察,调节焦距看清镜台测微尺的刻度;
3.移动镜台测微尺,同时转动目镜,使目镜测微尺与镜 台测微尺平行靠近,并将两尺的“0”点刻度线或某 刻度线对齐.然后从左向右查看两尺刻度线另一重 合处,记录重合线间目镜测微尺与镜台测微尺的格 数.按下式计算目镜测微尺每格等于多少微米。
精选课件
22
目镜测微尺的标定
n×a X=
M
X:目镜测微尺每格的实际长度 a:镜台测微尺每格的实际长度 n:镜台测微尺的刻度数。 M:目镜测微尺的刻度数。
精选课件
23
4.移去镜台测微尺,换血涂片,目镜测微 尺测量细胞所占小格数X目镜测微尺每小 格代表的实际长度=被测细胞的实际长度。
精选课件
24
实验报告
血涂片的制备和细胞大小的测量
精选课件
1
目的要求
1.掌握血涂片的制备方法; 2.认识红细胞及各种白细胞的典型形态; 3.掌握显微测微尺的使用方法。
精选课件
2
实验原理
❖ 涂片技术是制备血液样品最常用的技术。将血 液样品制成单层细胞的涂片标本,染色后可对 血液中各种细胞形态进行形态观察、细胞计数、 细胞大小测量等工作。
嗜中性粒细胞
精选课件
16
嗜酸性粒细胞
精选课件
17
嗜碱性粒细胞
精选课件
18
显微测微尺的使用
❖ 显微测微尺是用来测量在显微镜下所观察到的 物体的长度、面积的工具,包括镜台测微尺、 目镜测微尺两部分。